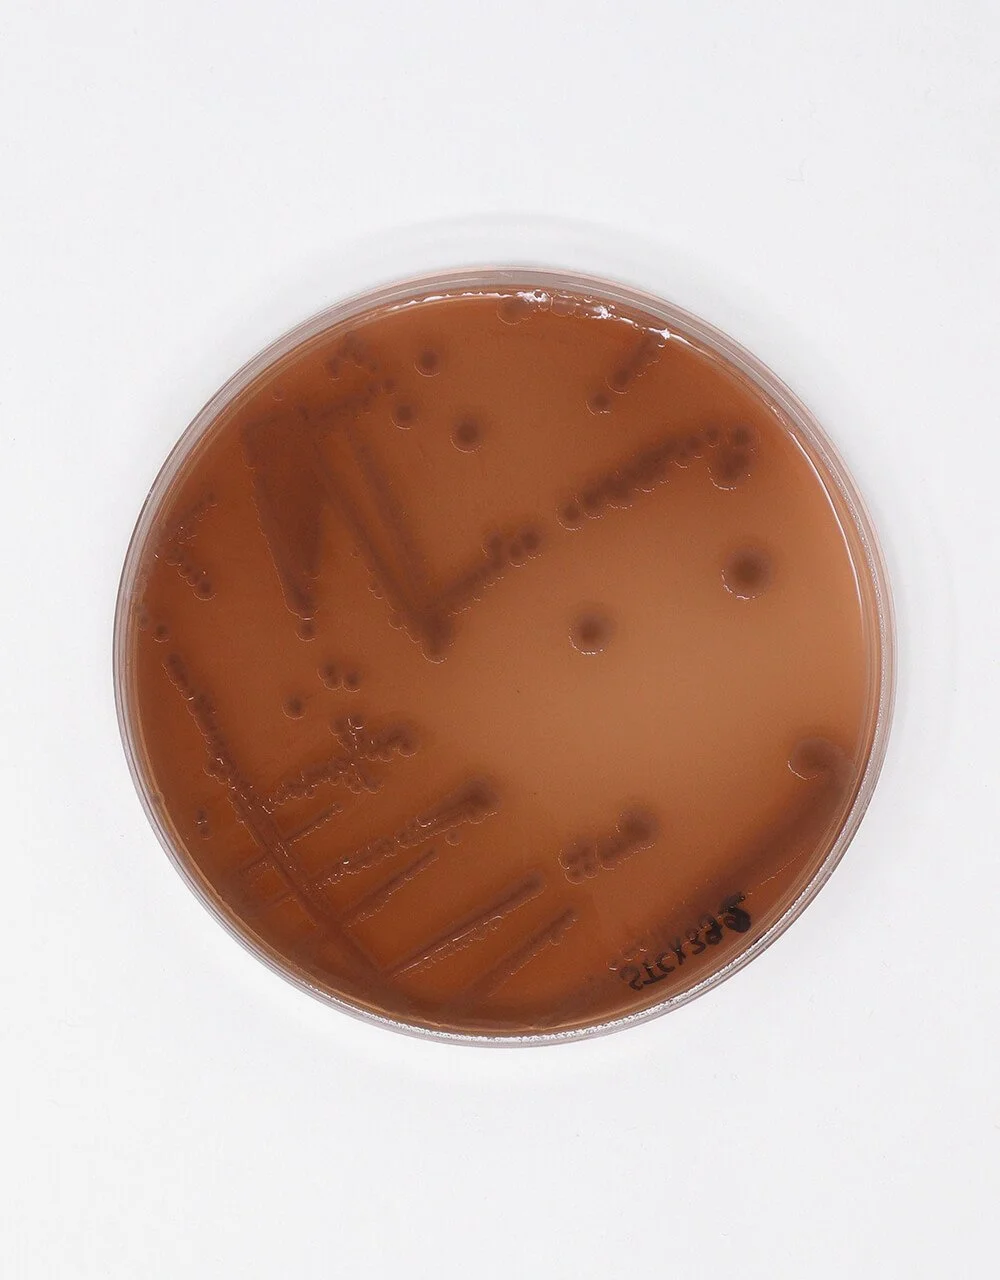

How Colorifix are using DNA code to create natural colours for clothes
Dyeing clothes is a toxic, wasteful process that harms the environment – one team of scientists is changing the future of fabric
At Parley, we’re always thinking about the future. What can the world look like? How can it be improved? How can we not just live in harmony with nature, but learn from it? We are aware that we cannot simply recycle our way out of the plastic crisis – we need to redesign the structures and systems that pollute our planet, along with the harmful materials that we’ve become addicted to. It’s why we’re calling for a Material Revolution – we have to change the way we make things in order to create the future. This new Parley series will meet the innovators and scientists who are trying to remodel our material world.
If you look inside your wardrobe at all the differently coloured garments, you’ll see hidden stories within those clothes. According to the UN, it takes around 3,781 liters of water to make just one pair of jeans, from the water required to grow crops and make the product, to the toxic chemicals used to dye the fabric. While the negative impact that fast fashion has on our planet is now well documented and understood (despite consumer habits not changing), a lesser talked about part of the process is the intensive usage of water needed to create clothes’ colour. According to the World Resources Institute, we use five trillion litres of water annually just to dye clothes and the textile industry is responsible for a fifth of the world’s water pollution. 72 different toxic chemicals have been identified in rivers and streams that come directly from the textile industry, dumped there due to a lack of regulation, substances that don’t go away. This careless method means that chemicals accumulate in waterways, affecting photosynthesis, harming plants and animals, making water unsafe to drink. Simply put, this cannot continue.
Enter Colorifix. The UK-based company formed in 2016 after seeing firsthand the ways that dyeing can have grave consequences for the environment. Founders Orr Yarkoni and Jim Ajioka were working in Nepal, developing biosensors to help monitor water quality. While there they began to understand the devastation that dyeing can wreak on our water systems, and set about using the technology that they were using to try and fix the issue.
Colorifix is a biotechnology company that uses nature as a solution. The team identifies an organism that has an interesting colour and then uses DNA databases to find the code responsible for “making that colour”. They then engineer microbes to create tiny “colour factories”, where the microbes then transfer the pigments to fabrics. This method uses no harmful substances and dramatically reduces water usage, making it truly revolutionary given the toxic techniques that we currently employ all over the world.
They say that working with these pigments isn’t just better for the environment, it’s more enjoyable and creative too. “One of the really fun things about working with natural colors is that they all have a story,” says Orr Yarkoni. “For instance our product Solar Glow, which is yellow, was found for the first time in the American Civil War. They found it in the wounds of soldiers that survived and didn’t contract gangrene - these microbes were glowing at night, healing the wounds of the injured. They called it “the angel’s glow” - given that it comes from the same organism and in homage to how it was discovered, we called the product Solar Glow.”
As of today, Colorifix has partnered with fashion brands like Pangaia and Vollebak, while it’s also received investment from the H&M group. So far, so good, but Colorifix are adamant that while there are still clothes being dyed using poisonous methods, there’s still work to be done. We visited the Colorifix lab in Norwich, on the east coast of the UK, to sit down with cofounder Orr Yarkoni, meet the team, and step inside the world of Colorifix.
Cofounders Jim Ajioka and Orr Yarkoni
Q&A
How exactly did Colorifix start, and why?
Colorifix came to exist from a passion for water quality. My co-founder Jim and I were working on biosensors – microbes that would change color if water wasn't safe to drink. Through that work we became aware of how much impact putting color into textiles has on the environment. So we decided to apply the base technology we were using to change the color of the microbes, to change the color of the fabric, and rather than monitor how much pollution this makes, actually solve it.
I'd love to know a bit more about your own origin story too – have you always been passionate about the environment?
Colorifix started at Cambridge University. Jim, my co-founder, was my boss at the time, and he gave me some leeway to look into this on evenings and weekends when I wasn't working on biosensors for water quality. It took a couple of years of evening and weekend work, but we successfully validated that this does work on lots of materials and at different stages of dying. Then we started the journey of setting up a company. As for myself, I've always been a huge fan of nature. That's why I went into science to begin with and why I went into synthetic biology specifically – to understand how nature works and essentially how DNA is life's language. The sad realization that so much of the world that I experienced as a child is already threatened or going extinct really scares me. From an early age, I really wanted to dedicate my work in science towards the environment. I'm very happy to be able to contribute in some way today.
It's been nearly ten years since Colorifix formed. Did you have a trajectory, or specific goals in mind when you started? And do you consider yourselves on track now?
As a general rule in life, I'd say everything takes longer than you expect. We started in 2016, it took us about two years to get funding, then it took us a few more years to build a team, facility and infrastructure. As you've seen today, we now have products in a wide range of colors. When we started we only really had two, and we're now at a stage where we're dying tons of fabric at a time, rather than a few grams. We've come a long way. There's still most of the journey to go because until we're dyeing most of the fabric in the world, there's still a reason for us to exist.
I'm fascinated by your technique of using the existing DNA codes of existing organisms to create specific colors. How did you discover or figure out that process?
We know that things in nature make colors and people have been sequencing everything from living or dead samples for decades now. We avoid having to go through physical samples, living or dead animals as it were, and go to these databases that are freely available and look for the message in the DNA to make the color. It starts with looking at things in nature that make color and are interesting. Then we go into the DNA and find what part we are actually interested in copying and putting into our microbe. The base for this type of technology has existed since the late eighties, but only in the very late 2000s, early 2010s, did it become accessible enough to do these things at scale and low cost.
How does the research process for your colors work? I know that you work with naturally occurring colors, but there are so many of those. How are you scouring the world looking for inspiration?
It all starts with looking for colors that can give us performance, because we're interested in making more sustainable products, not just greener ones. That means that they need to last just as long as the synthetics that we're replacing. So we look at lightfastness, washfastness and rubfastness and then we select from the ones that perform and begin borrowing the DNA code for making that dye. Then, we put it into our microorganism and from there, put it into fabric and check the performance again. Because we're using new chemistry we check for cytotoxicity, skin contact dermatitis and allergenicity because we don't want to repeat the mistakes that the old industry has made. We want to learn from them and start clean because that's the best chance of keeping it that way.
Do you have a favorite pigment that you've successfully engineered, and if so, why?
I know it's not a very exciting one but I’d say melanin. You find it in our skin and hair and in pretty much every mammal that you see in the world. I find that one particularly exciting because it serves many different purposes – protection from sunlight, generation of heat, even in some cases it can generate electricity. We see applications for our pigments in many different areas and I still believe that melanin is used everywhere in nature for a reason – we'll find more uses for it rather than just color.
“It starts with looking at things in nature that make color and are interesting. Then we go into the DNA and find what part we are interested in copying and putting into our microbe.”
Orr Yarkoni — Cofounder, Colorifix
Are there any organisms that you've tried to engineer using the DNA codes but it hasn't worked? And if so, what reason would that be?
When we engineer the microorganisms, quite often the first time we do it doesn't really work. Sometimes there are other pieces of machinery in the cell that the color normally comes from in a plant that isn't there in the microbe, so then we need to add that machinery to the microbe. The first time that we went to make the blue, which actually comes from the indigo plant, we weren't seeing a result. We had to make some modifications to make it very, very faint blue. Then we made it better and better and better until we achieved the blues that you see now. It's a continuous improvement process that often starts with “it didn't work”. The first time we produced Solar Glow, it made 0.3 picograms per liter. That's the minimum amount you can really detect in a liquid, it's invisible. Now we're close to a gram a liter. So you go millions of times more color as you continue the development. There are plenty of colors that we haven't cracked yet. The most important ones for us are black, navy and green because those are the colors that are typically difficult to achieve in the industry and are quite in demand. Obviously white too, even though it's not quite a color. It's a key one for us.
Why is black so difficult?
In nature, black is typically a structural color. It's a lot of different particles of different sizes, each one making a different color, but altogether they absorb all of the light, making it black. The reason that melanin sometimes looks black is because you have lots of tiny particles of melanin, and also big particles of melanin together that absorb all of the wavelengths. So if you put them individually, they look brown. When you put them together, they look black. Most of the time in nature, when you see black, it's structural. And the reason is if it's a chemical compound that's absorbing all of that light energy, it breaks down faster because color, the way it works is light hits the compound that gives it color and some of the energy comes back as light, meaning the color that you see and the rest of the energy that's absorbed has to be broken down into heat. And that over time breaks down the molecule that gives it the color. So the darker the color, typically the more energy it's absorbing and the faster it breaks down. And that's why nature, instead of having to constantly make this molecule to keep a material black, makes a structural color that doesn't break down because it's a physical property rather than a chemical one.
“Much like with plastics, I imagine that someday in the future we'll be looking at some of the things we've been dumping in the ocean for decades that should never have entered the water to begin with.”
Orr Yarkoni — Cofounder, Colorifix
You've worked with fashion brands such as Pangaia, while H&M have invested in Calx too. Do you think that your technology will become standard in the textile and fashion industries? How long do you think before it truly scales?
That is certainly our goal. We want to introduce this technology across every area of textile production where you need color – be it cotton, wool, polyester, or nylon. It will take us more time to get there. It's taken us almost 10 years to get to where we are today, where we're making tons. However, I would like us to get to the point where we're making millions of tons a year, as it’s the only way that we are going to make a real impact on a global scale. I believe it could take another ten years for this to take over a significant portion of the dyeing done in the industry. There's a lot of work ahead for us but thankfully we're not working alone. We're working with other people in the industry, and the idea isn't to change how everything works, it's just to change one part. That's why we believe we can do it.
What do you consider the barriers to scaling to be? What do you think is in your way?
The biggest one is uncertainty. We need to show that we can replace more and more products that people are making, meaning we need to have black and white and we need to have all the colors for all the different materials. The industry has worked in a certain way for a very, very long time. It's been almost 50 years since there's been any new dyeing chemistry. Changing people's minds is the hardest thing that takes the longest. However, once you have a product that people can see, touch and validate that ‘yes, this really is just as good’, it'll become easier and easier to convince people. We think that it's a fight that will get easier as we go along. Changing mindsets, convincing people to do something differently than how they've done it since the time of their grandparents, that's still the hardest thing.
Do you perceive the fashion industry to be an important communication tool for wider issues around things like the climate?
I think that fashion has always been a focal point for communication around innovation worldwide. Fashion touches everything from growing cotton in fields, to making all of the chemicals to make the dyes and putting them on the fabric. Fashion touches every type of industry and people from every walk of life.
I think it's a very powerful communication tool, and that's why brands become brands because fashion brings people together and addresses multiple topics, not just what people wear.
Do you think people are really aware of how damaging wastewater from the textile industry is, in the same way they are about plastic pollution?
I think we're only scratching the surface of how much long-term impact this industry has. Much like with plastics, I imagine that someday in the future we'll be looking at some of the things we've been dumping in the ocean for decades that should never have entered the water to begin with. Fixing that will be a whole other problem.
The key to fixing that is to stop putting those things in water as soon as possible, and what we're trying to do is provide a solution. Awareness needs to go up a lot. We believe it will in time, once we understand better just how much impact these things have on the environment, just like we're discovering with microplastics.
What other innovations in the biofabrication space are you excited by?
There's a whole range of really exciting innovations coming into textiles. Practices like lab-grown cotton and mycelium leather. There are specific challenges with the new materials because they need to meet all of those quality specs, price and scale, which is really tough to do. However, it's really good to see less stuff being made for the sake of making stuff and more and more production becoming on demand, responding to consumer needs rather than just what they think is going to be fashionable two years from now. Changes in material and changes in manufacturing behavior are all going to have an added impact reduction – no one solution will do everything.